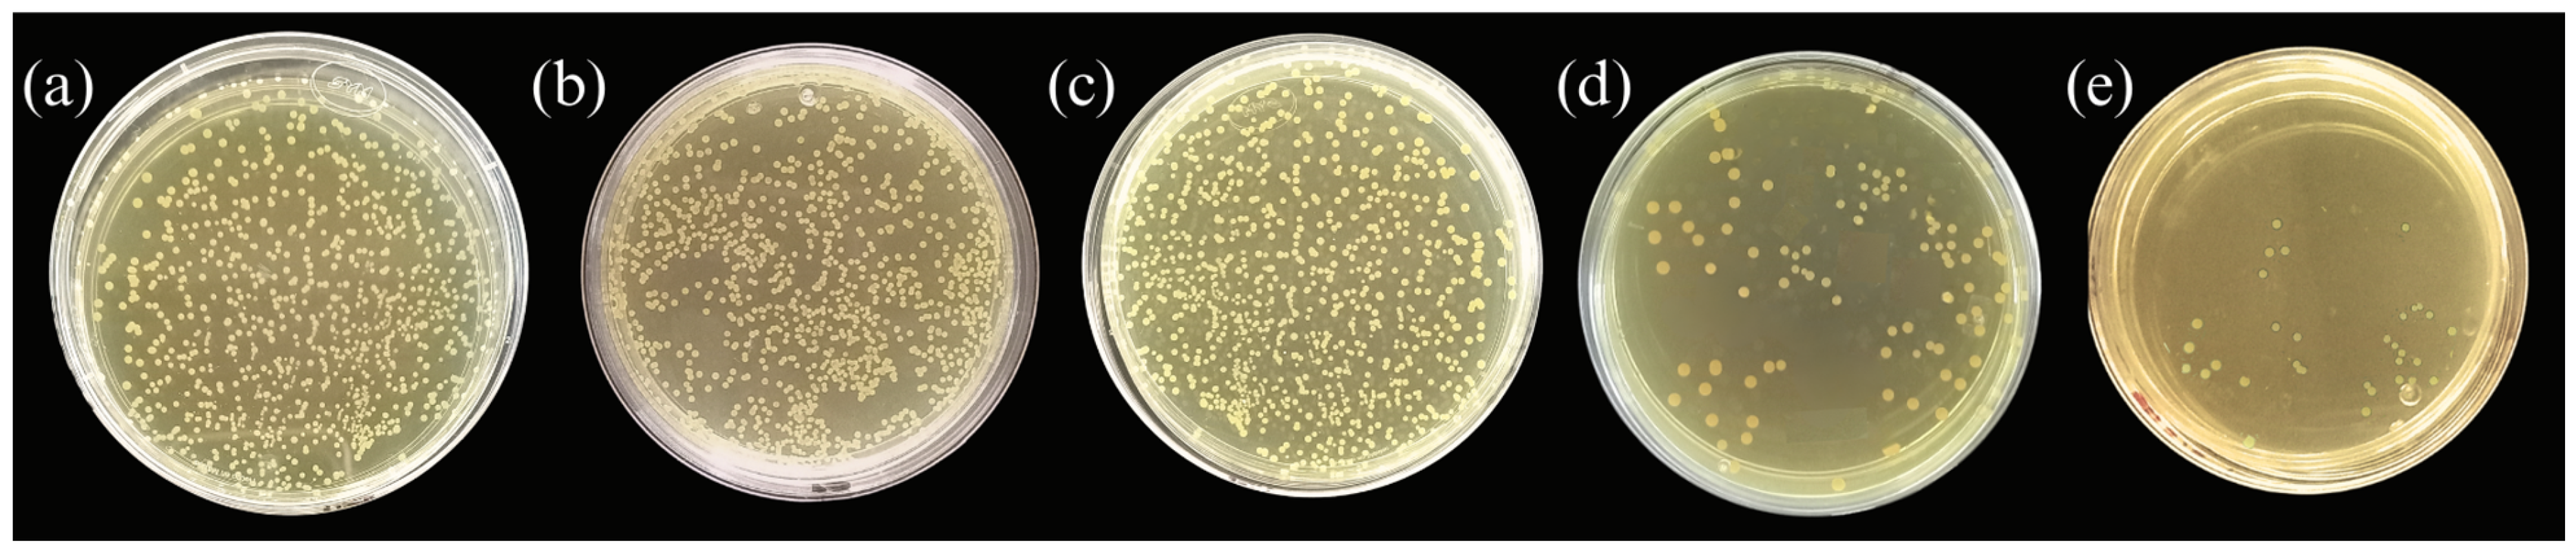
Waste 02 00007 g006

Sustainable Filters with Antimicrobial Action from Sugarcane Bagasse: A Novel Waste Utilization Approach
Abstract
:1. Introduction
2. Materials and Methods
2.1. Materials
2.2. Sugarcane Bagasse Preparation
2.3. Cellulose Extraction
2.4. Beads Preparation
2.5. Bead Characterization
2.5.1. Size and Sphericity
2.5.2. Water Activity and Moisture Content
2.5.3. FTIR Spectroscopy
2.5.4. Encapsulation Efficiency
2.5.5. Release Studies
2.6. Antimicrobial Activity
2.6.1. Well-Diffusion Assay
2.6.2. Dilution Assay (In Bead Column) Analysis
2.7. Statistical Analysis
3. Results and Discussion
3.1. Sugarcane Bagasse (SCB) Pretreatment
3.2. Cellulose Extraction
3.3. Structural Characterization of Beads
3.3.1. Bead Characterization
3.3.2. Encapsulation Efficiency
3.3.3. FTIR Spectroscopy
3.4. Eugenol Release
3.5. Antibacterial Activity
3.5.1. Well-Diffusion Assay
3.5.2. Dilution Assay (Bead Column) Analysis
4. Conclusions
Author Contributions
Funding
Institutional Review Board Statement
Informed Consent Statement
Data Availability Statement
Acknowledgments
Conflicts of Interest
References
- Shahi, N.; Min, B.; Sapkota, B.; Rangari, V.K. Eco-Friendly Cellulose Nanofiber Extraction from Sugarcane Bagasse and Film Fabrication. Sustainbility 2020, 12, 6015. [Google Scholar] [CrossRef]
- Sun, J.X.; Sun, X.F.; Zhao, H.; Sun, R.C. Isolation and characterization of cellulose from sugarcane bagasse. Polym. Degrad. Stab. 2004, 84, 331–339. [Google Scholar] [CrossRef]
- Arkoun, M.; Daigle, F.; Holley, R.A.; Heuzey, M.C.; Ajji, A. Chitosan-based nanofibers as bioactive meat packaging materials. Packag. Technol. Sci. 2018, 31, 185–195. [Google Scholar] [CrossRef]
- Sihite, R.E.M.; Fahma, F.; Sailah, I.; Yunus, M.; Kusumaatmaja, A.; Mukti, R.R.; Kadja, G.T.M. Production and characterization of PVA/alginate composite filament with cellulose from oil palm empty fruit bunches. In Proceedings of the IOP Conference Series: Earth and Environmental Science, Bogor, Indonesia, 9–10 October 2019; IOP Publishing: Bristol, UK, 2020; Volume 472, p. 012015. [Google Scholar]
- Tian, F.; Chen, W.; Wu, C.E.; Kou, X.; Fan, G.; Li, T.; Wu, Z. Preservation of Ginkgo biloba seeds by coating with chitosan/nano-TiO2 and chitosan/nano-SiO2 films. Int. J. Biol. Macromol. 2019, 126, 917–925. [Google Scholar] [CrossRef]
- Youssef, A.M.; El-Sayed, S.M. Bionanocomposites materials for food packaging applications: Concepts and future outlook. Carbohydr. Polym. 2018, 193, 19–27. [Google Scholar] [CrossRef]
- de Farias, B.S.; Sant’Anna Cadaval Junior, T.R.; de Almeida Pinto, L.A. Chitosan-functionalized nanofibers: A comprehensive review on challenges and prospects for food applications. Int. J. Biol. Macromol. 2019, 123, 210–220. [Google Scholar] [CrossRef] [PubMed]
- Sayed, A.; Safwat, G.; Abdel-raouf, M.; Mahmoud, G.A. Alkali-cellulose/Polyvinyl alcohol biofilms fabricated with essential clove oil as a novel scented antimicrobial packaging material. Carbohydr. Polym. Technol. Appl. 2023, 5, 100273. [Google Scholar] [CrossRef]
- Paris, M.J.; Ramírez-Corona, N.; Palou, E.; López-Malo, A. Modelling release mechanisms of cinnamon (Cinnamomum zeylanicum) essential oil encapsulated in alginate beads during vapor-phase application. J. Food Eng. 2020, 282, 110024. [Google Scholar] [CrossRef]
- Lorenzo-Leal, A.C.; Palou, E.; López-Malo, A. Evaluation of the efficiency of allspice, thyme and rosemary essential oils on two foodborne pathogens in in-vitro and on alfalfa seeds, and their effect on sensory characteristics of the sprouts. Int. J. Food Microbiol. 2019, 295, 19–24. [Google Scholar] [CrossRef]
- Ribes, S.; Ruiz-Rico, M.; Moreno-Mesonero, L.; Moreno, Y.; Barat, J.M. Natural antimicrobial compounds immobilised on silica microparticles as filtering materials: Impact on the metabolic activity and bacterial viability of waterborne microorganisms. Environ. Technol. Innov. 2021, 21, 101219. [Google Scholar] [CrossRef]
- Dikić, J.; Lukić, I.; Pajnik, J.; Pavlović, J.; Hrenović, J.; Rajić, N. Antibacterial activity of thymol/carvacrol and clinoptilolite composites prepared by supercritical solvent impregnation. J. Porous Mater. 2021, 28, 1577–1584. [Google Scholar] [CrossRef]
- Peña-Gómez, N.; Ruiz-Rico, M.; Fernández-Segovia, I.; Barat, J.M. Study of apple juice preservation by filtration through silica microparticles functionalised with essential oil components. Food Control 2019, 106, 106749. [Google Scholar] [CrossRef]
- Papafotopoulou-Patrinou, E.; Gialleli, A.I.; Kallis, M.; Plessas, S.; Alexopoulos, A.; Mantzourani, I.; Bezirtzoglou, E.; Bekatorou, A.; Kanellaki, M.; Koutinas, A.A. Microbiological assessment of tubular cellulose filters used for liquid foods cold pasteurization. LWT—Food Sci. Technol. 2016, 67, 151–158. [Google Scholar] [CrossRef]
- Feng, Y.H.; Cheng, T.Y.; Yang, W.G.; Ma, P.T.; He, H.Z.; Yin, X.C.; Yu, X.X. Characteristics and environmentally friendly extraction of cellulose nanofibrils from sugarcane bagasse. Ind. Crops Prod. 2018, 111, 285–291. [Google Scholar] [CrossRef]
- Jo, Y.J.; Chun, J.Y.; Kwon, Y.J.; Min, S.G.; Hong, G.P.; Choi, M.J. Physical and antimicrobial properties of trans-cinnamaldehyde nanoemulsions in water melon juice. LWT—Food Sci. Technol. 2015, 60, 444–451. [Google Scholar] [CrossRef]
- Chan, E.S.; Lee, B.B.; Ravindra, P.; Poncelet, D. Prediction models for shape and size of Ca-alginate macrobeads produced through extrusion-dripping method. J. Colloid Interface Sci. 2009, 338, 63–72. [Google Scholar] [CrossRef]
- Hernández-Nava, R.; López-Malo, A.; Palou, E.; Ramírez-Corona, N.; Jiménez-Munguía, M.T. Complex Coacervation Between Gelatin and Chia Mucilage as an Alternative of Encapsulating Agents. J. Food Sci. 2019, 84, 1281–1287. [Google Scholar] [CrossRef]
- Zhao, Y.; Wang, Y.; Zhang, Z.; Li, H. Advances in Controllable Release Essential Oil Microcapsules and Their Promising Applications. Molecules 2023, 28, 4979. [Google Scholar] [CrossRef]
- Hasheminejad, N.; Khodaiyan, F.; Safari, M. Improving the antifungal activity of clove essential oil encapsulated by chitosan nanoparticles. Food Chem. 2019, 275, 113–122. [Google Scholar] [CrossRef] [PubMed]
- Arrioja-Bretón, D.; Mani-López, E.; Palou, E.; López-Malo, A. Antimicrobial activity and storage stability of cell-free supernatants from lactic acid bacteria and their applications with fresh beef. Food Control 2020, 115, 107286. [Google Scholar] [CrossRef]
- Peña-Gómez, N.; Ruiz-Rico, M.; Pérez-Esteve, É.; Fernández-Segovia, I.; Barat, J.M. Novel antimicrobial filtering materials based on carvacrol, eugenol, thymol and vanillin immobilized on silica microparticles for water treatment. Innov. Food Sci. Emerg. Technol. 2019, 58, 102228. [Google Scholar] [CrossRef]
- Alizadeh Asl, S.; Mousavi, M.; Labbafi, M. Synthesis and Characterization of Carboxymethyl Cellulose from Sugarcane Bagasse. J. Food Process. Technol. 2017, 8, 8. [Google Scholar] [CrossRef]
- Tsai, F.H.; Kitamura, Y.; Kokawa, M. Effect of gum arabic-modified alginate on physicochemical properties, release kinetics, and storage stability of liquid-core hydrogel beads. Carbohydr. Polym. 2017, 174, 1069–1077. [Google Scholar] [CrossRef] [PubMed]
- Li, Y.; Wen, J.; Xue, Z.; Yin, X.; Yuan, L.; Yang, C. Removal of Cr(VI) by polyaniline embedded polyvinyl alcohol/sodium alginate beads−Extension from water treatment to soil remediation. J. Hazard. Mater. 2022, 426, 127809. [Google Scholar] [CrossRef]
- Shlosman, K.; Rein, D.M.; Shemesh, R.; Koifman, N.; Caspi, A.; Cohen, Y. Encapsulation of Thymol and Eugenol Essential Oils Using Unmodified Cellulose: Preparation and Characterization. Polymer 2022, 15, 95. [Google Scholar] [CrossRef]
- Montero, Y.; Souza, A.G.; Oliveira, É.R.; dos Santos Rosa, D. Nanocellulose functionalized with cinnamon essential oil: A potential application in active biodegradable packaging for strawberry. Sustain. Mater. Technol. 2021, 29, e00289. [Google Scholar] [CrossRef]
- Sarmento, B.; Ribeiro, A.; Veiga, F.; Sampaio, P.; Neufeld, R.; Ferreira, D. Alginate/chitosan nanoparticles are effective for oral insulin delivery. Pharm. Res. 2007, 24, 2198–2206. [Google Scholar] [CrossRef] [PubMed]
- Ruiz-Gonzalez, N.; Lopez-Malo, A.; Palou, E.; Ramirez-Corona, N.; Jimenez-Munguia, M.T. Antimicrobial activity and physicochemical characterization of oregano, thyme and clove leave essential oils, nonencapsulated and nanoencapsulated, using emulsification. Appl. Food Biotechnol. 2019, 6, 237–246. [Google Scholar]
- Baiya, C.; Nannuan, L.; Tassanapukdee, Y.; Chailapakul, O.; Songsrirote, K. The Synthesis of Carboxymethyl Cellulose-Based Hydrogel from Sugarcane Bagasse Using Microwave-Assisted Irradiation for Selective Adsorption of Copper(II) Ions. Environ. Prog. Sustain. Energy 2019, 38, S157–S165. [Google Scholar] [CrossRef]
- Qiao, Y.; Han, Y.; Guan, R.; Liu, S.; Bi, X.; Liu, S.; Cui, W.; Zhang, T.; He, T. Inorganic hollow mesoporous spheres-based delivery for antimicrobial agents. Front. Mater. Sci. 2023, 17, 230631. [Google Scholar] [CrossRef]
- Lee, J.H.; Yeo, Y. Controlled drug release from pharmaceutical nanocarriers. Chem. Eng. Sci. 2015, 125, 75–84. [Google Scholar] [CrossRef]
- Costa, P.; Sousa Lobo, J.M. Modeling and comparison of dissolution profiles. Eur. J. Pharm. Sci. 2001, 13, 123–133. [Google Scholar] [CrossRef]
- Chen, K.; Brennan, C.; Cao, J.; Cheng, G.; Li, L.; Qin, Y.; Chen, H. Characterization of chitosan/eugenol-loaded IRMOF-3 nanoparticles composite films with sustained antibacterial activity and their application in postharvest preservation of strawberries. LWT 2023, 186, 115270. [Google Scholar] [CrossRef]
- Cheng, J.; Wang, H.; Kang, S.; Xia, L.; Jiang, S.; Chen, M.; Jiang, S. An active packaging film based on yam starch with eugenol and its application for pork preservation. Food Hydrocoll. 2019, 96, 546–554. [Google Scholar] [CrossRef]
- Liburdi, K.; Benucci, I.; Palumbo, F.; Esti, M. Lysozyme immobilized on chitosan beads: Kinetic characterization and antimicrobial activity in white wines. Food Control 2016, 63, 46–52. [Google Scholar] [CrossRef]
- Gómez-Llorente, H.; Fernández-Segovia, I.; Pérez-Esteve, É.; Ribes, S.; Rivas, A.; Ruiz-Rico, M.; Barat, J.M. Immobilization of Natural Antimicrobial Compounds on Food-Grade Supports as a New Strategy to Preserve Fruit-Derived Foods. Foods 2023, 12, 2060. [Google Scholar] [CrossRef] [PubMed]
- Ruiz-Rico, M.; García-Ríos, E.; Barat, J.M.; Guillamón, J.M. Microbial stabilisation of white wine by filtration through silica microparticles functionalised with natural antimicrobials. LWT 2021, 149, 111783. [Google Scholar] [CrossRef]

| C0 | E1 (1%) | C1 (1%) | C2 (0.5%) | C3 (0.1%) | |
|---|---|---|---|---|---|
| D (mm) | 2.18 ± 0.29 B | 2.19 ± 0.25 B | 2.37 ± 0.43 AB | 2.62 ± 0.37 A | 2.66 ± 0.43 A |
| SF (mm) | 0.118 ± 0.021 AB | 0.062± 0.038 B | 0.157 ± 0.095 A | 0.118 ± 0.057 AB | 0.117 ± 0.078 AB |
| aw | 0.970 ± 0.01 D | 0.988 ± 0.092 A | 0.979 ± 0.089 C | 0.982 ± 0.101 B | 0.978 ± 0.096 C |
| MC % (db) | 93.48 ± 0.18 A | 92.66 ± 0.11 B | 92.67 ± 0.01 B | 93.78 ± 0.06 A | 93.5 ± 0.19 A |
| E1 (1%) | C1 (1%) | C2 (0.5%) | C3 (0.1%) | |
|---|---|---|---|---|
| Encapsulation Efficiency % | 84.82 ± 0.29 C | 93.29 ± 0.31 A | 70.01 ± 0.23 D | 85.15 ± 0.21 B |
| C1 (1%) | C2 (0.5%) | C3 (0.1%) | |
|---|---|---|---|
| 1/C0 | 2.3703 ± 0.9829 C | 4.8498 ± 1.2711 B | 10.5430 ± 3.8006 A |
| k, (%v/v)−1(min)−1 | 1.020 ± 0.0124 A | 0.1292 ± 0.0161 C | 0.4420 ± 0.0481 B |
| R2 | 0.8806 | 0.8898 | 0.9028 |
| C0 | E1 (1%) | C1 (1%) | C2 (0.5%) | C3 (0.1%) | |
|---|---|---|---|---|---|
| Inhibition halo (mm) | ND | 18.16 ± 5.99 AB | 20.47 ± 0.14 A | 13.18 ± 0.43 B | 12.82 ± 0.968 B |
Disclaimer/Publisher’s Note: The statements, opinions and data contained in all publications are solely those of the individual author(s) and contributor(s) and not of MDPI and/or the editor(s). MDPI and/or the editor(s) disclaim responsibility for any injury to people or property resulting from any ideas, methods, instructions or products referred to in the content. |
© 2024 by the authors. Licensee MDPI, Basel, Switzerland. This article is an open access article distributed under the terms and conditions of the Creative Commons Attribution (CC BY) license (https://creativecommons.org/licenses/by/4.0/).
Share and Cite
Hernández-López, R.; López-Malo, A.; Navarro-Amador, R.; Ramírez-Corona, N. Sustainable Filters with Antimicrobial Action from Sugarcane Bagasse: A Novel Waste Utilization Approach. Waste 2024, 2, 122-135. https://doi.org/10.3390/waste2010007
Hernández-López R, López-Malo A, Navarro-Amador R, Ramírez-Corona N. Sustainable Filters with Antimicrobial Action from Sugarcane Bagasse: A Novel Waste Utilization Approach. Waste. 2024; 2(1):122-135. https://doi.org/10.3390/waste2010007
Chicago/Turabian StyleHernández-López, Rosa, Aurelio López-Malo, Ricardo Navarro-Amador, and Nelly Ramírez-Corona. 2024. "Sustainable Filters with Antimicrobial Action from Sugarcane Bagasse: A Novel Waste Utilization Approach" Waste 2, no. 1: 122-135. https://doi.org/10.3390/waste2010007






